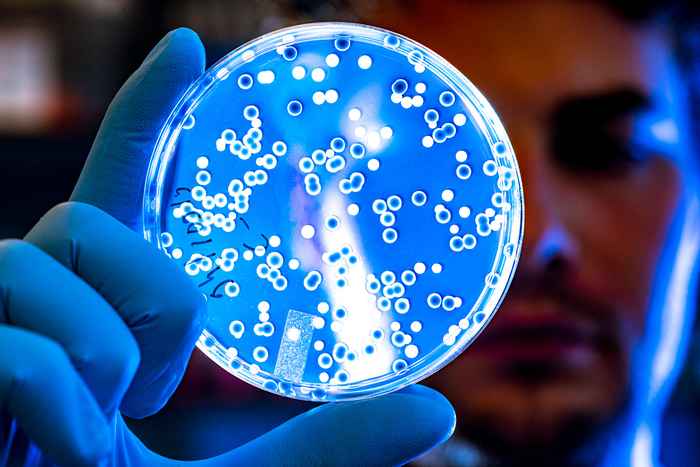

Resistente schimmel bezig aan wereldwijde opmars
13 december 2023
Van oppervlakkige eczeem tot fatale bloedinfecties. Jaarlijks raken meer dan een miljard mensen besmet met schimmels en 1,6 miljoen mensen sterft aan een infectie. 'Een dramatische toename in een periode van tien jaar', volgens de Jong, die zich voor zijn onderzoek vooral richt op ziekteverwekkende Candida-schimmels. 'We zien een verschuiving van infecties veroorzaakt door candida-soorten die goed te behandelen zijn, naar resistente soorten die bedreigend zijn, met Candida auris als een van de beruchtste besmetters.'
Mysterie
Waar de schimmel vandaan komt, is vooralsnog een mysterie. De Jong zoekt naar aanwijzingen in het DNA en gedrag van Candida auris. 'We vermoeden dat zeewater een belangrijke rol speelt', zegt hij. ‘Omdat de schimmel een hele hoge tolerantie voor zout heeft, iets waar veel schimmels niet goed tegen kunnen. De zee zou ook een goede verklaring zijn voor de wereldwijde verspreiding van Candida auris, via de stromingen zou de soort zich over de hele wereld kunnen verspreiden.'
Alarmerend
Die verspreiding is alarmerend, volgens de Jong. 'De schimmel veroorzaakt een uitzonderlijk hoog sterftecijfer onder risicogroepen en er is geen goede behandeling voor. Het is een sterke schimmel die zichzelf snel aanpast, naast een hoge tolerantie voor zout kan de schimmel bijvoorbeeld ook goed tegen relatief hoge temperaturen en veel gebruikte desinfectiemiddelen.'
In het ziekenhuis
Vrijwel alle besmettingen vinden in het ziekenhuis plaats. 'Tijdens een operatie krijgt de schimmel de kans het lichaam in te gaan.' Waar patiënten de schimmel oplopen is niet bekend. 'Dat zal niet in het ziekenhuis zelf zijn, waarschijnlijk dragen patiënten de schimmel al langere tijd met zich mee.'
Verklaringen
Verklaringen voor de snelle opkomst zijn er wel. ‘Die liggen vooral in de enorme medische stappen die zijn gezet in de afgelopen decennia. Er is een hele grote groep mensen die door kan leven met ziektes die ons eerder vaker fataal werden. De keerzijde daarvan is dat die groep vaak een sterk verminderd immuunsysteem heeft en dan ben je veel vatbaarder voor infecties. Het is volgens De Jong dan ook zaak om te werken aan het tijdig detecteren en bestrijden van de schimmel. ‘Mijn onderzoek brengt de unieke eigenschappen van deze Candida-soort in kaart. Nu zien we nog veel misdiagnose in het ziekenhuis wat zorgt voor verkeerde of te late behandeling van schimmelinfecties. Dat inperken, begint bij het herkennen en begrijpen van de schimmel.’
Promotiegegevens
Auke de Jong verdedigt zijn proefschrift 'Fungal Pathogens Exposed. Novel insights into Candida auris and emerging relatives of the Candida haemulonii species complex' op 22 december in de Agnietenkapel in Amsterdam.